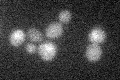
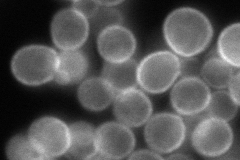
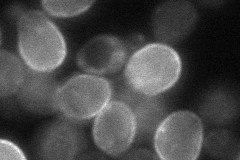

View description
Plasma membrane ATP-binding cassette (ABC) transporter, weak-acid-inducible multidrug transporter required for weak organic acid resistance; induced by sorbate and benzoate and regulated by War1p; mutants exhibit sorbate hypersensitivity
Localization:
Intensity:
Fold change:
Significance:
-
C’ GFP library in SD
below threshold16.25 -
N' NOP1pr-GFP in SD
cell periphery144.108 -
N' TEF2pr-mCherry in SD

cell periphery,vacuole119.973 -
N' NATIVEpr-GFP in SD

cell periphery28.7058 -
N' TEF2pr-VC and Cyto-VN in SD
cell periphery52.3667 -
C’ GFP library in SD+DTT

cytosol17.191.05No -
C’ GFP library in SD+H2O2

cytosol16.791.03No -
C’ GFP library in Starvation Media

cytosol15.120.92No -
C’ GFP library on the background of Pup2-DaMP

N/A -
C’ GFP library on the background of CCT mutant

N/A0N/AYes
